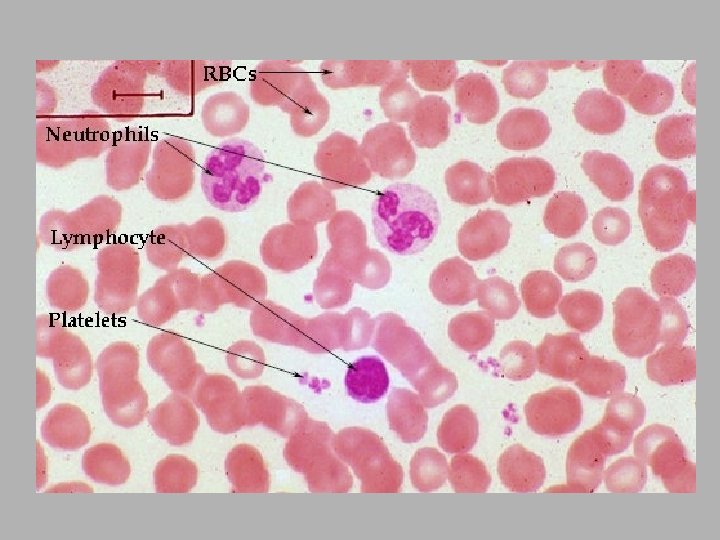

El cuerpo humano contiene alrededor de 5 litros

- Slides: 16
El cuerpo humano contiene alrededor de 5 litros de sangre, que supone un 7% del peso del cuerpo. Hematocrito: Los glóbulos rojos constituyen alrededor de un 45% de este volumen y los glóbulos blancos alrededor de un 1%, el resto es el plasma sanguíneo líquido
Leishman / Wrights / Giemsa Stain (azul de metileno y eosina, p. H 6. 8) TIPO CELULAR COLOR eritrocitos Rojo a anaranjado neutrófilos Púrpura oscuro, núcleo multilobulado, citoplasma rosa pálido con gránulos rojo-lila Núcleo azul, citoplasma rosa pálido, gránulos rojo eosinófilos anaranjado Núcleo púrpura-azul oscuro, gránulos púrpura oscuro (casi basófilos negros) Núcleos púrpura oscuro-púrpura azulado, citoplasma azul linfocitos cielo plaquetas Gránulos violeta a púrpura
Leucocitos granulares Neutrófilos( 50 -70%) Basófilos(0 -2%) Eosinófilos (0 -5%) Leucocitos agranulares Monocitos (1 -9%) Linfocitos(20 -40%)
Neutrófilos 12 -15 mm A: Enzimas lisosómicas B. Colagenasa, lisozima, etc
Eosinófilos Gránulos: MBP, peroxidasas, enzimas lisosómicas
Basófilos Gránulos: histamina, heparina, enzimas lisosómicas, etc
Monocitos 12 -18 mm Gránulos: hidrolasas ácidas (lisosomas)
Linfocitos 5 -15 mm
Migración de leucocitos en la respuesta inflamatoria Capilares más permeables Adhesión leucocitos a células endoteliales Quimiotaxis leucocitos a tejido Entrada señales a sangre que estimulan médula ósea: Infecciones bacterianas (neutrófilos) Protozoos (eosinófilos)
Plaquetas Gránulos: Alfa: PDGF Delta: serotonina 2 -4 mm Citoesqueleto: actina, miosina
Eritrocitos 7 mm Hemoglobina Citoesqueleto: espectrina, anquirina, proteina 4. 1 Membrana: banda 3, glucoforina
Células sanguíneas Tipo celular Funciones Globulos rojos (eritrocitos) Transportan O 2 y. CO 2 Neutrófilos Fagocitosis bacterias Eosinófilos Respuesta alérgica/histaminasa Respuesta infecciones parasitarias Basófilos Liberación heparina, histamina y serotonina Células/ml 5 x 106 5 x 103 2 x 102 4 x 10 Monocitos Conversión en macrófagos (células de Kupffer, osteoclastos) 4 x 102 Linfocitos B Fabrican anticuerpos Linfocitos T Matan células infectadas por virus y regulan actividad de otros leucocitos 2 x 103 1 x 103 Células NK Matan células infectadas por virus y algunas células tumorales 1 x 102 Plaquetas Coagulación/serotonina/PDGF 3 x 105
Neutrófilo Basófilo Eosinófilo Monocito